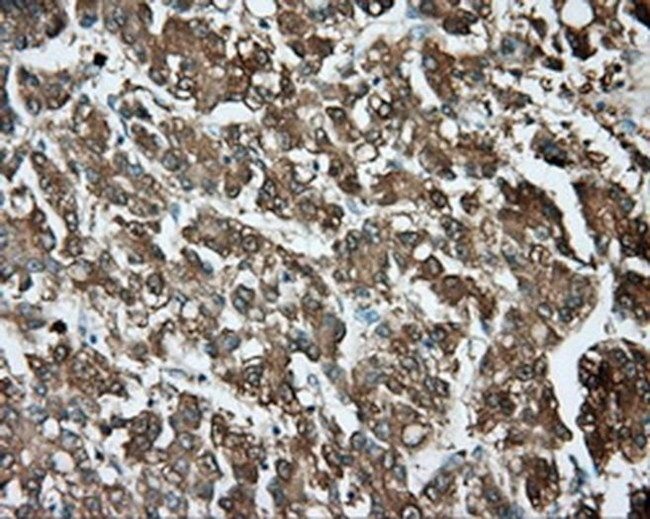
TPMT Antibody in Immunohistochemistry (Paraffin) (IHC (P))

Search
Invitrogen
TPMT Monoclonal Antibody (OTI4C1)
{{$productOrderCtrl.translations['antibody.pdp.commerceCard.promotion.promotions']}}
{{$productOrderCtrl.translations['antibody.pdp.commerceCard.promotion.viewpromo']}}
{{$productOrderCtrl.translations['antibody.pdp.commerceCard.promotion.promocode']}}: {{promo.promoCode}} {{promo.promoTitle}} {{promo.promoDescription}}. {{$productOrderCtrl.translations['antibody.pdp.commerceCard.promotion.learnmore']}}
图: 1 / 5
TPMT Antibody (MA5-25074) in IHC (P)





Please note: We are reviewing Western blot images included in the antibody testing data in our catalog, including those provided by third parties. Unless expressly labeled or annotated as “raw-unedited”, Western blot images included in the antibody testing data in our catalog may have been edited, optimized or otherwise adjusted for presentation.
产品信息
MA5-25074
种属反应
宿主/亚型
分类
类型
克隆号
抗原
偶联物
形式
浓度
规格
纯化类型
保存液
内含物
保存条件
运输条件
RRID
靶标信息
Catalyzes the S-methylation of thiopurine drugs such as 6-mercaptopurine. Defects in TPMT are the cause of thiopurine S-methyltransferase deficiency (TPMT deficiency). TPMT is an enzyme involved in the normal metabolic inactivation of thiopurine drugs. These drugs are generally used as immunosupressants or cytotoxic drugs and are prescribed for a variety of clinical conditions including leukemia, autoimmune disease and organ transplantation. Patients with intermediate or no TPMT activity are at risk of toxicity after receiving standard doses of thiopurine drugs and it is shown that inter-individual differences in response to these drugs are largely determined by genetic variation at the TPMT locus.
仅用于科研。不用于诊断过程。未经明确授权不得转售。
篇参考文献 (0)
生物信息学
蛋白别名: HGNC:12014; Thiopurine methyltransferase; Thiopurine S-methyltransferase; truncated thiopurine methyltransferase
基因别名: TPMT
UniProt ID: (Dog) Q8HX86
Entrez Gene ID: (Dog) 403536